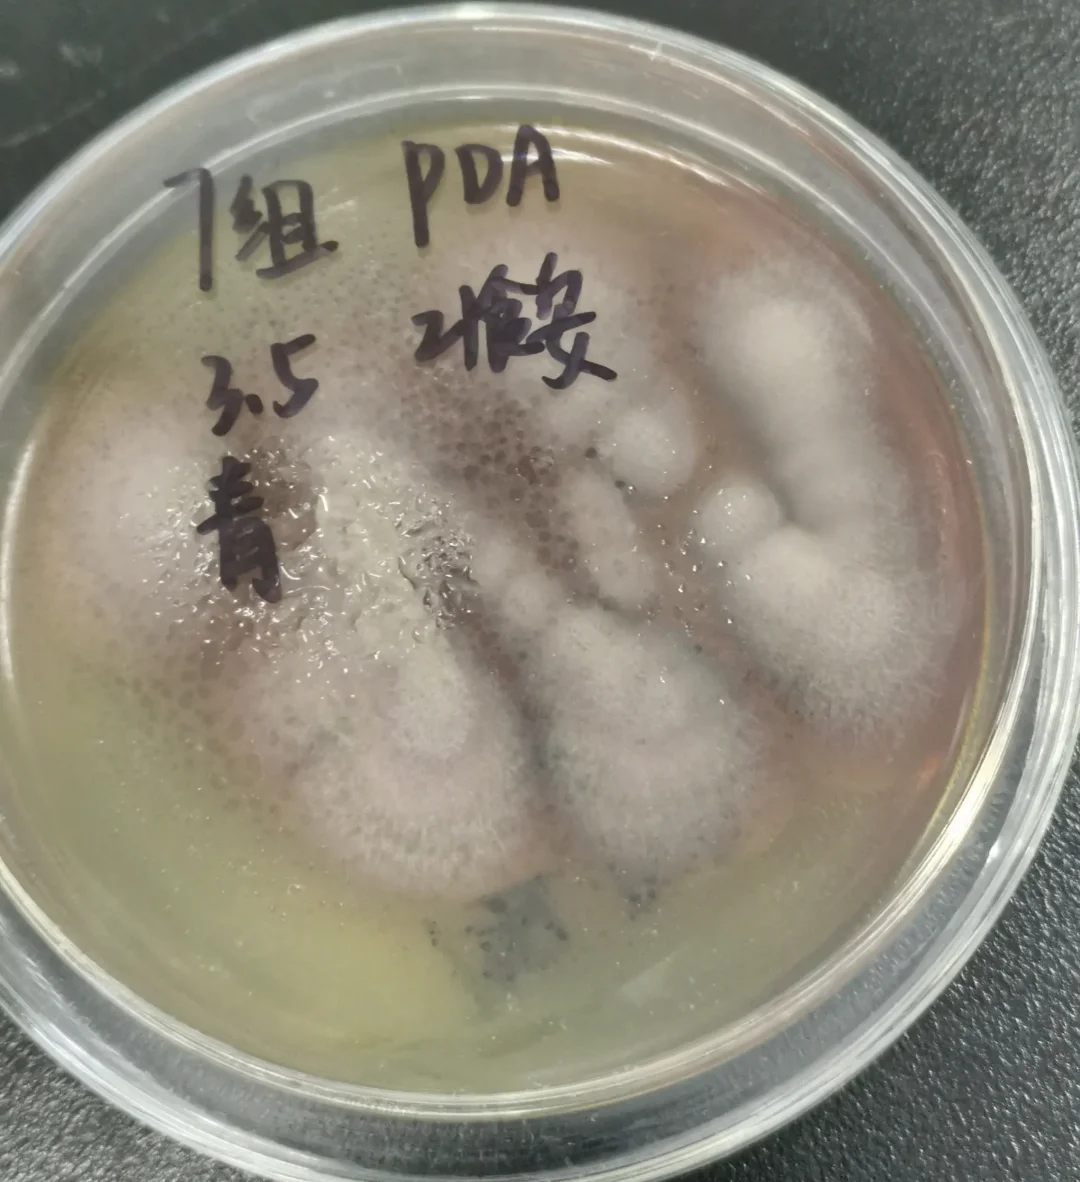
什么是霉菌?

右下眼皮跳是什么原因
眼皮负责闭眼的工作,由围绕眼睛的眼轮匝肌所构成而我们所说的眼皮跳,其实就是控制眼皮肌肉的神经不正常兴奋所引起,也就是部份的眼轮匝肌肌纤维在短时间内不能自主地持续收缩,以致牵动其上的皮肤 抢首赞 评论 分享 举报 为你...
安宫牛黄丸治疗脑梗塞的效果
物理治疗等安宫牛黄丸的效果因人而异,不可盲目依赖医生指导的重要性使用任何药物前,患者及家属应与医生充分沟通,明确药物作用风险及注意事项医生会根据患者情况制定个性化方案,包括是否使用安宫牛黄丸对于脑梗塞昏迷患者,及时就...
请问胸部长痤疮严重,看图片,像这样的能治
此外,饮食高糖高脂情绪压力化妆品使用不当等可能诱发或加重病情临床表现主要累及面部胸部背部等皮脂溢出部位,表现为多形性皮损,包括粉刺白头粉刺黑头粉刺丘疹脓疱结节囊肿等炎症性皮损常伴疼痛,严重时可遗留瘢痕,影响美观诊断与...
肠梗阻有哪些典型症状
肠梗阻早期症状主要有以下方面腹痛通常是阵发性绞痛,持续数分钟至数小时不等疼痛部位多位于脐周或上腹部,随后可能逐渐转移至下腹部这种腹痛可能会在排气或排便后有所缓解,但不久后可能再次出现阵发性绞痛是肠梗阻早期较为典型的症...

京公网安备11000000000001号
京ICP备11000001号